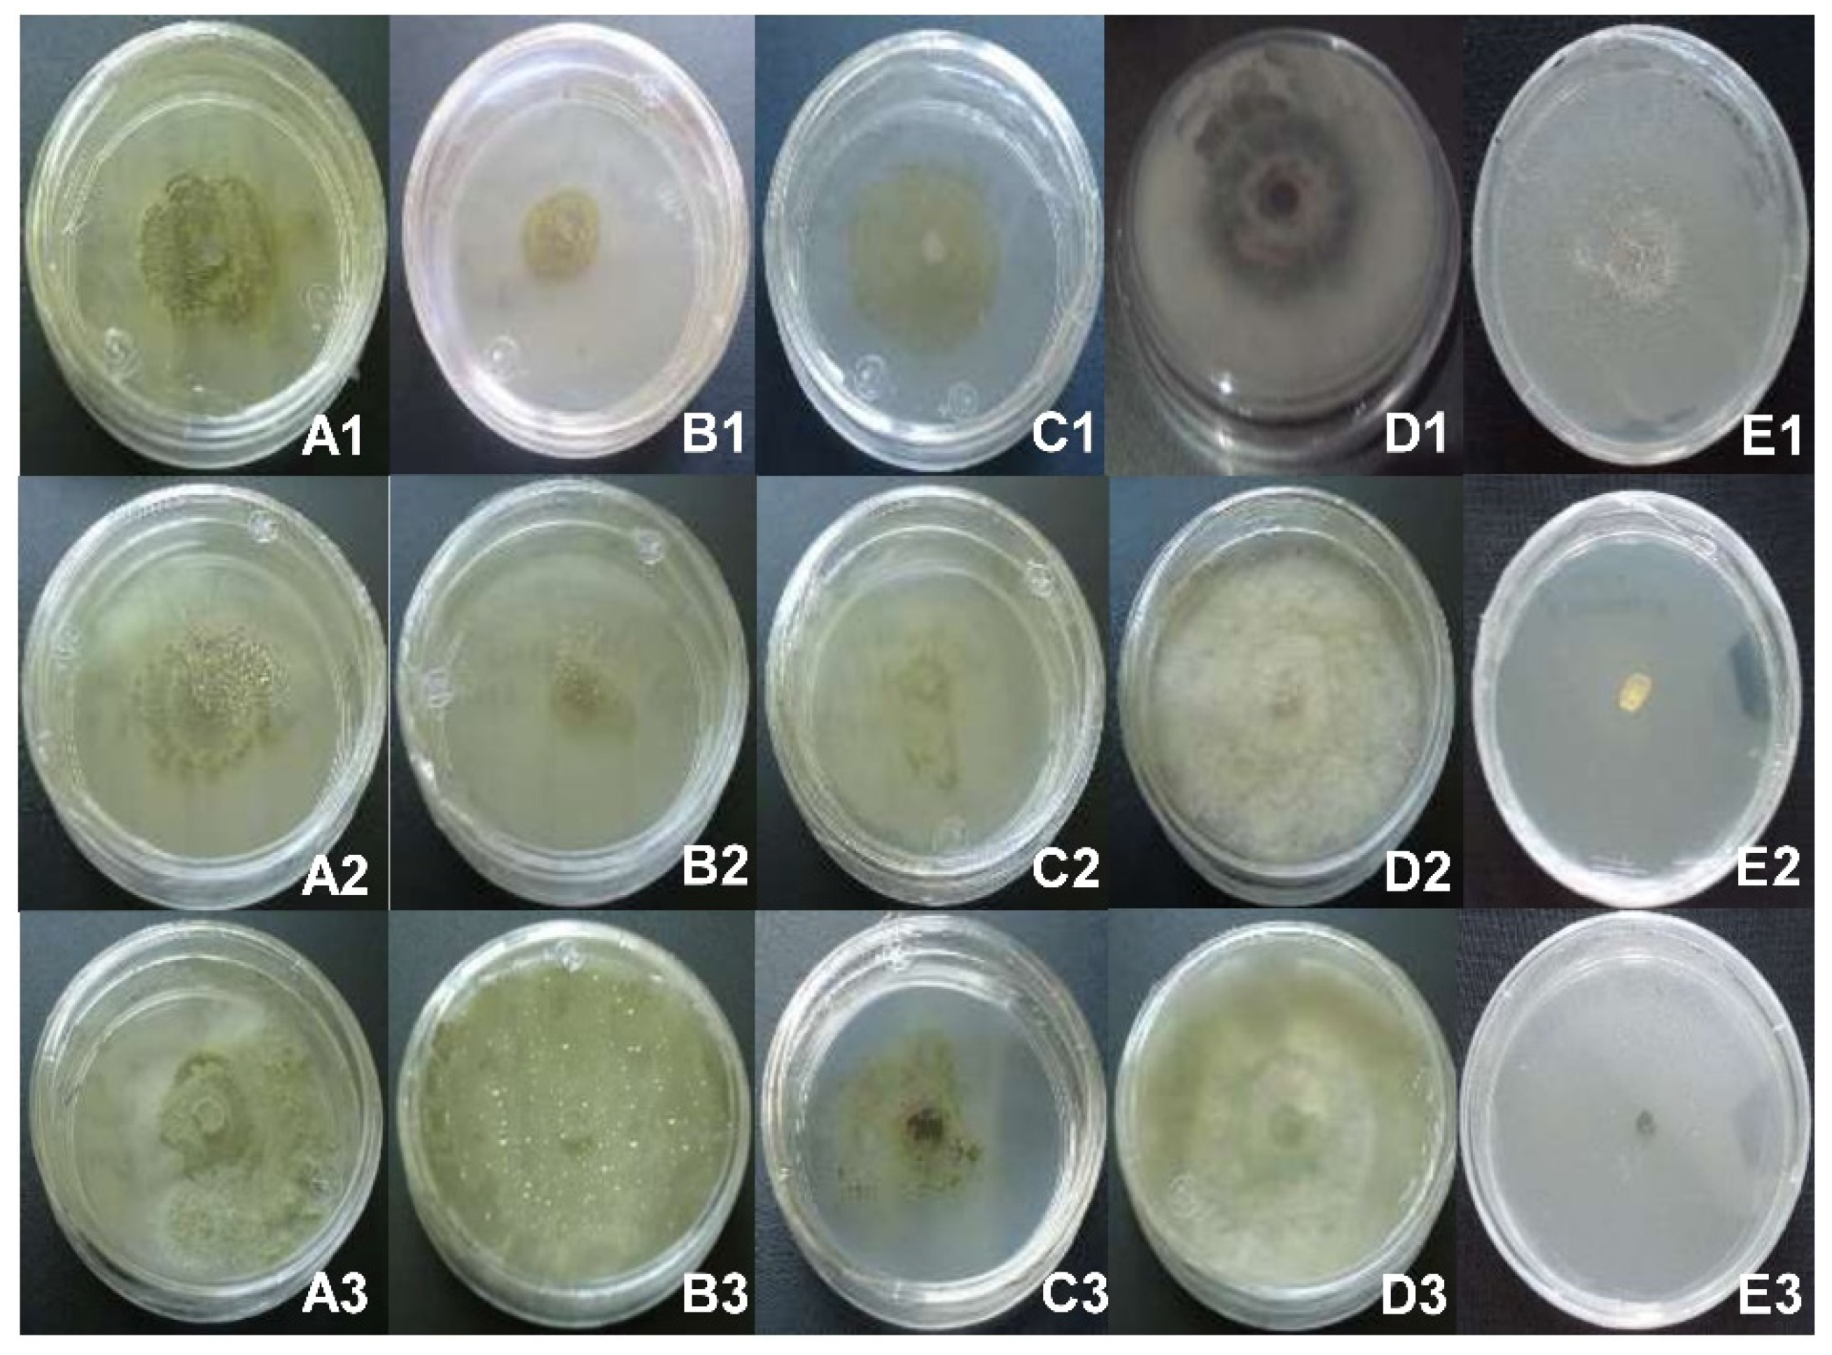
Plants 10 00852 g001 Plants 10 00852 g001

In Vitro Antifungal Activity of Plant Extracts on Pathogenic Fungi of Blueberry (Vaccinium sp.)
Abstract
1. Introduction
2. Material and Methods
2.1. Isolation of Pathogenic Fungi of Blueberry
2.2. Molecular Identification of Fungi
2.3. Pathogenicity Tests
2.4. Collection and Identification of Plants
2.5. Obtaining Crude Extracts and Fractions
2.6. Antifungal Activity Assays
2.7. Identification of Bioactive Secondary Metabolites
2.8. Statistical Analysis
3. Results
3.1. Identification of Pathogenic Fungi of Blueberry and Pathogenicity Tests
3.2. Antifungal Effect In Vitro of Crude Extracts on the Mycelial Growth of Blueberry Pathogens
3.3. Fractions of Crude Extracts and Identification of Bioactive Compounds
4. Discussion
5. Conclusions
Author Contributions
Funding
Institutional Review Board Statement
Informed Consent Statement
Data Availability Statement
Acknowledgments
Conflicts of Interest
References
- SIAP-SAGARPA. Servicio de Información Agroalimentaria y Pesquera-Secretaría de Agricultura, Ganadería, Desarrollo Rural, Pesca y Alimentación. Available online: https://nube.siap.gob.mx/cierreagricola/ (accessed on 16 March 2021).
- Bristow, P.; Ramsdell, D. Botrytis blight. In Compendium of Blueberry and Cranberry Diseases; Caruso, F., Ramsdell, D., Eds.; Amer Phytopathological Society: St. Paul, MN, USA, 1995; pp. 8–9. [Google Scholar]
- Wharton, P.S.; Schilder, A.C. Novel infection strategies of Colletotrichum acutatum on ripe blueberry fruit. Plant Pathol. 2008, 57, 122–134. [Google Scholar] [CrossRef]
- Espinoza, J.G.; Briceño, E.X.; Keith, L.M.; Latorre, B.A. Canker and twig dieback of blueberry caused by Pestalotiopsis spp. and a Truncatella sp. in Chile. Plant Dis. 2008, 92, 1407–1414. [Google Scholar] [CrossRef]
- Sammonds, J.; Billones, R.; Rocchetti, M.; Ridgway, H.J.; Walter, M.; Jaspers, M.V. Survey of blueberry farms for Botryosphaeria dieback and crown rot pathogens. N. Z. Plant Prot. 2009, 62, 238–242. [Google Scholar] [CrossRef]
- Kong, C.S.; Qiu, X.L.; Yi, K.S.; Yu, X.F.; Yu, L. First Report of Neofusicoccum vitifusiforme Causing Blueberry Blight of Blueberry in China. Plant Dis. 2010, 94, 1373. [Google Scholar] [CrossRef] [PubMed]
- Díaz, P.; Cabrera, A.; Alem, D.; Larrañaga, P.; Ferreira, F.; Rizza, M.D. Antifungal activity of medicinal plant extracts against phytopathogenic fungus Alternaria spp. Chil. J. Agric. Res. 2011, 71, 231–239. [Google Scholar] [CrossRef]
- Mdee, L.K.; Masoko, P.; Eloff, J.N. The activity of extracts of seven common invasive plant species on fungal phytopathogens. S. Afr. J. Bot. 2009, 75, 375–379. [Google Scholar] [CrossRef]
- Salgado-Garciglia, R.; Molina-Torres, J.; López-Meza, J.E.; Loeza-Lara, P.D. Efecto del extracto crudo y los compuestos bioactivos de Heliopsis longipes sobre la incidencia de la antracnosis, micorrización y nodulación del frijol. Agrociencia 2008, 42, 679–687. [Google Scholar]
- Ribera, A.E.; Zuñiga, G. Induced plant secondary metabolites for phytopatogenic fungi control: A review. J. Soil Sci. Plant Nutr. 2012, 12, 893–911. [Google Scholar] [CrossRef]
- Madariaga-Mazón, A.; Hernández-Alvarado, R.B.; Noriega-Colima, K.O.; Osnaya-Hernández, A.; Martinez-Mayorga, K. Toxicity of secondary metabolites. Phys. Sci. Rev. 2019, 4, 1–11. [Google Scholar] [CrossRef]
- Montes-Belmont, R.; Cruz-Cruz, V.; Martínez-Martínez, G.; Sandoval-García, G.; García-Licona, R.; Zilch-Domínguez, S.; Bravo-Luna, L.; Bermúdez-Torres, K.; Flores-Moctezuma, H.E.; Carvajal-Moreno, M. Propiedades antifúngicas en plantas superiores. Análisis retrospectivo de investigaciones. Rev. Mex. Fitopatol. 2000, 18, 125–131. [Google Scholar]
- López-Villafranco, M.E.; Aguilar-Contreras, A.; Aguilar-Rodríguez, S.; Xolalpa-Molina, S. Las Verbenaceae empleadas como recurso herbolario en México: Una revisión etnobotánica-médica The Verbenaceae used as an herbal resource in Mexico: An ethnobotanical-medical review. Polibotánica 2017, 44, 195–216. [Google Scholar] [CrossRef]
- Reyes, F.D.; Peña, C.J.; Canales, M.; Jiménez, M.; Meráz, S.; Hernandez, T. Antimicrobial activity of Argemone ochroleuca Sweet (Chicalote). Boletín Latinoam. Caribe Plantas Med. Aromáticas 2011, 10, 139–146. [Google Scholar]
- Villareal, J.Á.; Villaseñor, J.L. Flora de Veracruz. Compositae. Tribu Tageteae; Sosa, V., Ed.; Instituto de Ecología, A.C.: Xalapa, Veracruz, México, 2005. [Google Scholar]
- Agrios, G. Plant Pathology, 5th ed.; Elsevier Academic Press: Amsterdam, The Netherlands, 2005; ISBN 0080473784. [Google Scholar]
- Raeder, U.; Broda, P. Rapid preparation of DNA from filamentous fungi. Lett. Appl. Microbiol. 1985, 1, 17–20. [Google Scholar] [CrossRef]
- Barrera-Necha, L.L.; Bautista-Baños, S. Actividad Antifúngica de Polvos, Extractos y Fracciones de Cestrum nocturnum L. Sobre el Crecimiento Micelial de Rhizopus stolonifer (Ehrenb.:Fr.) Vuill. Rev. Mex. Fitopatol. 2008, 26, 27–31. [Google Scholar]
- Castillo, F.; Hernández, D.; Gallegos, G.; Mendez, M.; Rodríguez, R.; Reyes, A.; Aguilar, C.N. In vitro antifungal activity of plant extracts obtained with alternative organic solvents against Rhizoctonia solani Kühn. Ind. Crops Prod. 2010, 32, 324–328. [Google Scholar] [CrossRef]
- Barrera-Figueroa, B.E.; Loeza-Lara, P.D.; Hernández-García, A.; López-Mesa, J.E.; Molina-Torres, J.; del Río-Torres, R.E.N.; Martínez-Pacheco, M.M.; López-Gómez, R.; Salgado-Garciglia, R. Antibacterial activity of flower extracts from Helenium mexicanum H.B.K. Emir. J. Food Agric. 2011, 23, 258–264. [Google Scholar]
- Waksmundzka-Hajnos, M.; Sherma, J.; Kowalska, T. Overview of the Field of TLC in Phytochemistry and the Structure of the Book. In Thin Layer Chromatography in Phytochemistry; Waksmundzka-Hajnos, M., Sherma, J., Kowalska, T., Eds.; CRC Press: Boca Raton, FL, USA, 2008; p. 874. [Google Scholar]
- Sánchez-Pérez, J.D.L.; Jaimes-Lara, M.G.; Salgado-Garciglia, R.; López-Meza, J.E. Root extracts from Mexican avocado (Persea americana var. drymifolia) inhibit the mycelial growth of the oomycete Phytophthora cinnamomi. Eur. J. Plant Pathol. 2009, 124, 595–601. [Google Scholar] [CrossRef]
- Pandey, D.K.; Tripathi, N.N.; Tripathi, R.D.; Dixit, S.N. Fungitoxic and phytotoxic properties of the essential oil of Hyptis suaveolens. J. Plant Dis. Prot. 1982, 89, 344–349. [Google Scholar]
- Adams, R.P. Identification of Essential Oil Components by Gas Chromatography/Mass Spectrometry, 4th ed.; Allured Publishing Corporation: Carol Stream, IL, USA, 2007. [Google Scholar]
- Ruiz-Sánchez, E.; Mejía-Bautista, M.A.; Cristóbal-Alejo, J.; Valencia-Botín, A.; Reyes-Ramírez, A. Actividad antagónica de filtrados de Bacillus subtilis contra Colletotrichum gloeosporioides (Penz.). Rev. Mex. Cienc. Agrícolas 2014, 5, 1325–1332. [Google Scholar] [CrossRef][Green Version]
- Mondragón, F.A.; López, M.J.; Ochoa, A.S.; Gutiérrez, C.M. Hongos Asociados a la Parte Aérea del Arándano en Los Reyes, Michoacán, México. Rev. Mex. Fitopatol. 2012, 30, 141–144. [Google Scholar]
- Sabaratnam, S. Blueberry Anthracnose (Ripe Rot); British Columbia Ministry of Agriculture: Abbotsford, BC, Canada, 2018.
- Tovar-Pedraza, J.M.; Mora-Aguilera, J.A.; Nava-Díaz, C.; Téliz-Ortiz, D.; Valdovinos-Ponce, G.; Villegas-Monter, Á.; Hernández-Morales, J. Identification, pathogenicity, and histopathology of lasiodiplodia theobromae on mamey sapote grafts In Guerrero, México. Agrociencia 2012, 46, 147–161. [Google Scholar]
- Sandoval-Sánchez, M.; Nieto-Ángel, D.; Sandoval-Islas, J.S.; Téliz-Ortiz, D.; Orozco-Santos, M.; Silva-Rojas, H.V. Hongos asociados a pudrición del pedúnculo y muerte descendente del mango (Mangifera Indica L.). Agrociencia 2013, 47, 61–73. [Google Scholar]
- Kalidindi, N.; Thimmaiah, N.V.; Jagadeesh, N.V.; Nandeep, R.; Swetha, S.; Kalidindi, B. Antifungal and antioxidant activities of organic and aqueous extracts of Annona squamosa Linn. leaves. J. Food Drug Anal. 2015, 23, 795–802. [Google Scholar] [CrossRef]
- Juárez, Z.N.; Hernández, L.R.; Bach, H.; Sánchez-Arreola, E.; Bach, H. Antifungal activity of essential oils extracted from Agastache mexicana ssp. xolocotziana and Porophyllum linaria against post-harvest pathogens. Ind. Crops Prod. 2015, 74, 178–182. [Google Scholar] [CrossRef]
- Praveen Kumar, P.; Kumaravel, S.; Lalitha, C. Screening of antioxidant activity, total phenolics and GC-MS study of Vitex negundo. African J. Biochem. Res. 2010, 4, 191–195. [Google Scholar]
- Boussaada, O.; Ammar, S.; Saidana, D.; Chriaa, J.; Chraif, I.; Daami, M.; Helal, A.N.; Mighri, Z. Chemical composition and antimicrobial activity of volatile components from capitula and aerial parts of Rhaponticum acaule DC growing wild in Tunisia. Microbiol. Res. 2008, 163, 87–95. [Google Scholar] [CrossRef] [PubMed]
- Maxia, A.; Falconieri, D.; Piras, A.; Porcedda, S.; Marongiu, B.; Frau, M.A.; Gonçalves, M.J.; Cabral, C.; Cavaleiro, C.; Salgueiro, L. Chemical Composition and Antifungal Activity of Essential Oils and Supercritical CO 2 Extracts of Apium nodiflorum (L.) Lag. Mycopathologia 2012, 174, 61–67. [Google Scholar] [CrossRef] [PubMed]
- Prajapati, M.; Patel, J.; Modi, K.; Shah, M. Leucas aspera: A review. Pharmacogn. Rev. 2010, 4, 85–87. [Google Scholar] [CrossRef]
- Green, E.; Obi, L.C.; Samie, A.; Bessong, P.O.; Ndip, R.N. Characterization of n-Hexane sub-fraction of Bridelia micrantha (Berth) and its antimycobacterium activity. BMC Complement. Altern. Med. 2011, 11, 28. [Google Scholar] [CrossRef] [PubMed]
- Xue-Na, B.; Cheng, J.; Liang, W.; Lan-Qing, M.; Yu-Bo, L.; Guang-Lu, S.; You-Nian, W. Antifungal activity of extracts by supercritical carbon dioxide extraction from roots of Stellera chamaejasme L. and analysis of their constituents using GC-MS. In Advances in Intelligent and Soft Computing; Zhu, E., Sambath, S., Eds.; Springer: Berlin/Heidelberg, Germany, 2012; Volume 134, pp. 653–662. ISBN 9783642275364. [Google Scholar]
- Vimalavady, A.; Kadavul, K. Phytocomponents identified on the various extracts of stem of Hugonia mystax L. (Linaceae). Pelagia Res. Libr. Eur. J. Exp. Biol. 2013, 3, 73–80. [Google Scholar]
- Elleuch, L.; Shaaban, M.; Smaoui, S.; Mellouli, L.; Karray-Rebai, I.; Fourati-Ben Fguira, L.; Shaaban, K.A.; Laatsch, H. Bioactive secondary metabolites from a new terrestrial streptomyces sp. TN262. Appl. Biochem. Biotechnol. 2010, 162, 579–593. [Google Scholar] [CrossRef] [PubMed]

| Extracts Ɛ | Concentration (mg/mL) | Inhibition (%) | |||
|---|---|---|---|---|---|
| P. clavispora | C. gloeosporioides | L. pseudotheobromae | |||
| M1L (EtOH) | 0.5, 1, 2 | 0 g | 0 j | 0 e | |
| 5 | 5.4 e | 55 b | 0 e | ||
| M5L (AcOEt) | 0.5, 1 | 0 g | 0 j | 0 e | |
| 2 | 0 g | 21 e | 0 e | ||
| L. hirta | 5 | 100 a | 100 a | 22 d | |
| M8Fl (AcOEt) | 0.5, 1, 2 | 0 g | 0 j | 0 e | |
| 5 | 24 c | 30 d | 0 e | ||
| M11Fl (EtOH) | 0.5, 1, 2, 5 | 0 g | 0 j | 0 e | |
| M3LFr (EtOH) | 0.5, 1, 2 | 0 g | 0 j | 0 e | |
| 5 | 59 b | 48 c | 0 e | ||
| M6LFr (AcOEt) | 0.5, 1, 2 | 0 g | 0 j | 0 e | |
| A. ochroleuca | 5 | 100 a | 100 a | 0 e | |
| M9R (AcOEt) | 0.5, 1, 2 | 0 g | 0 j | 0 e | |
| 5 | 4 f | 5 i | 0 e | ||
| M12R (EtOH) | 0.5, 1, 2, 5 | 0 g | 0 j | 0 e | |
| M2LS (EtOH) | 0.5, 1 | 0 g | 0 j | 0 e | |
| 2 | 0 g | 18 f | 0 e | ||
| 5 | 0 g | 100 a | 0 e | ||
| M4LS (AcOEt) | 0.5 | 0 g | 0 j | 0 e | |
| A. porophyllum | 1 | 0 g | 0 j | 79 c | |
| 2 | 0 g | 13 g | 83 b | ||
| 5 | 100 a | 100 a | 100 a | ||
| M7L (AcOEt) | 0.5, 1, 2 | 0 g | 0 j | 0 e | |
| 5 | 7 d | 10 h | 0 e | ||
| M10L (EtOH) | 0.5, 1, 2, 5 | 0 g | 0 j | 0 e | |
| Absolute control * | - | 0 g | 0 j | 0 e | |
| Negative control | - | 0 g | 0 j | 0 e | |
| Positive control | 5 | 100 a | 100 a | 100 a | |
| Fractions | Concentration (mg/mL) | Inhibition (%) | |
|---|---|---|---|
| P. clavispora | C. gloeosporioides | ||
| F1 | 1.8 | 0 e | 8.2 g |
| F2 | 1.8 | 0 e | 12.9 e |
| F3 | 1.8 | 0 e | 15.3 d |
| F4 | 2.4 | 0 e | 0 j |
| F5 | 1.8 | 0 e | 20.0 c |
| F6 | 2.4 | 11.0 b | 9.4 f |
| F7 | 1.8 | 0 e | 6.3 h |
| F8 | 1.2 | 10.6 c | 0 j |
| F9 | 2.4 | 10.6 c | 4.3 i |
| F10 | 0.6 | 2.0 d | 44.3 b |
| Absolute control * | - | 0 e | 0 j |
| Negative control | - | 0 e | 0 j |
| Positive control | 5 | 100 a | 100 a |
| Fractions | Concentration (mg/mL) | Inhibition (%) | |
|---|---|---|---|
| P. clavispora | C. gloeosporioides | ||
| F1 | 1.5 | 8.7 j | 4.0 n |
| F2 | 3.6 | 8.7 j | 18 g |
| F3 | 3 | 18.7 i | 6.7 m |
| F4 | 2.4 | 18.7 i | 12.0 j |
| F5 | 4.8 | 1.3 l | 8.0 l |
| F6 | 2.4 | 22.7 g | 20.7 e |
| F7 | 3 | 1.3 l | 24.0 c |
| F8 | 1.8 | 28.0 e | 20.0 f |
| F9 | 1.2 | 28.0 e | 21.3 d |
| F10 | 0.6 | 34.7 c | 20.0 f |
| F11 | 1.8 | 27.3 e | 26.0 b |
| F12 | 1.2 | 34.7 c | 18.0 g |
| F13 | 3 | 36.0 b | 16.0 h |
| F14 | 1.2 | 24.0 f | 22.0 d |
| F15 | 1.2 | 20.7 h | 13.3 i |
| F16 | 1.2 | 4.0 k | 10.0 k |
| F17 | 1.2 | 33.3 d | 20.0 f |
| Absolute control * | - | 0 m | 0 o |
| Negative control | - | 0 m | 0 o |
| Positive control | 5 | 100 a | 100 a |
| Fractions | Concentration (mg/mL) | Inhibition (%) | ||
|---|---|---|---|---|
| P. clavispora | C. gloeosporioides | L. pseudotheobromae | ||
| F1 | 6.6 | 29.8 c | 7.8 d | 4.7 d |
| F2 | 1.8 | 34.9 b | 6.7 e | 14.1 c |
| F3 | 3 | 14.9 e | 7.5 d | 14.1 c |
| F4 | 3 | 26.3 d | 12.2 b | 1.6 g |
| F5 | 3 | 11.0 f | 5.9 f | 16.1 b |
| F6 | 1.2 | 6.7 g | 7.5 d | 3.1 e |
| F7 | 2.4 | 6.7 g | 8.6 e | 2.8 f |
| F8 | 4.2 | 5.9 h | 6.7 e | 0 h |
| Absolute control * | - | 0 i | 0 g | 0 h |
| Negative control | - | 0 i | 0 g | 0 h |
| Positive control | 5 | 100 a | 100 a | 100 a |
Publisher’s Note: MDPI stays neutral with regard to jurisdictional claims in published maps and institutional affiliations. |
© 2021 by the authors. Licensee MDPI, Basel, Switzerland. This article is an open access article distributed under the terms and conditions of the Creative Commons Attribution (CC BY) license (https://creativecommons.org/licenses/by/4.0/).
Share and Cite
Hernández-Ceja, A.; Loeza-Lara, P.D.; Espinosa-García, F.J.; García-Rodríguez, Y.M.; Medina-Medrano, J.R.; Gutiérrez-Hernández, G.F.; Ceja-Torres, L.F. In Vitro Antifungal Activity of Plant Extracts on Pathogenic Fungi of Blueberry (Vaccinium sp.). Plants 2021, 10, 852. https://doi.org/10.3390/plants10050852
Hernández-Ceja A, Loeza-Lara PD, Espinosa-García FJ, García-Rodríguez YM, Medina-Medrano JR, Gutiérrez-Hernández GF, Ceja-Torres LF. In Vitro Antifungal Activity of Plant Extracts on Pathogenic Fungi of Blueberry (Vaccinium sp.). Plants. 2021; 10(5):852. https://doi.org/10.3390/plants10050852
Chicago/Turabian StyleHernández-Ceja, Abraham, Pedro Damián Loeza-Lara, Francisco Javier Espinosa-García, Yolanda M. García-Rodríguez, José Roberto Medina-Medrano, Germán Fernando Gutiérrez-Hernández, and Luis Fernando Ceja-Torres. 2021. "In Vitro Antifungal Activity of Plant Extracts on Pathogenic Fungi of Blueberry (Vaccinium sp.)" Plants 10, no. 5: 852. https://doi.org/10.3390/plants10050852
APA StyleHernández-Ceja, A., Loeza-Lara, P. D., Espinosa-García, F. J., García-Rodríguez, Y. M., Medina-Medrano, J. R., Gutiérrez-Hernández, G. F., & Ceja-Torres, L. F. (2021). In Vitro Antifungal Activity of Plant Extracts on Pathogenic Fungi of Blueberry (Vaccinium sp.). Plants, 10(5), 852. https://doi.org/10.3390/plants10050852

